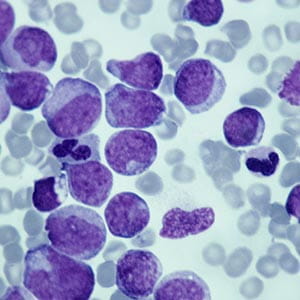
myeloid cell

Basic Science
In 2006, University Hospitals and Case Western Reserve University established the Case Cardiovascular Research Institute (CVRI). The CVRI is home to groundbreaking fundamental scientific discoveries that have reshaped medicine through cutting-edge bench science in cells to pre-clinical models and, ultimately, first-in-human studies. Our research programs are arguably the most comprehensive, entrepreneurial, and easily qualify as one of the nation’s most ambitious projects to develop next-generation discoveries in cardiovascular medicine and a new breed of physician-scientists.
The diversity and collaborative interactions within the CVRI and broader university community foster a multidisciplinary approach to basic and translational research. We set ourselves apart from other programs by embracing a strong culture of developing and promoting the careers of young scientists and physician-scientists in clinical, translational and basic research. The CVRI has maintained robust funding through multiple K-grants, including K99-R00 awards, R01s, prestigious R35 awards, and a continually active T32 Cardiovascular training grant. Although the portfolio of research in the CVRI is necessarily broad, a few areas are worth mentioning as these receive predominant attention.

Research efforts focus on the role of vascular cells in blood vessel development, angiogenesis, inflammation, injury and repair.

Research efforts are focused on understanding fundamental mechanisms governing the development, progression and complications of cardiac hypertrophy and failure.

Research efforts are directed towards understanding basic molecular mechanisms governing gene regulation with a focus on DNA-binding proteins and chromatin-modifying factors. Recent effort has focused on higher orders of epigenomic regulation including 3D-chromatin structure and its alterations in health and disease.
The main focus is on the role of innate immunity – especially the development, differentiation and activation of myeloid lineage cells and their impact on the development of atherosclerosis, myocardial infarction, and insulin resistance syndromes.

Using cardiac electrophysiological and pharmacological techniques, research efforts are focused on understanding mechanisms underlying the development of atrial flutter/fibrillation and novel pharmacologic and mechanical approaches to the treatment of this arrhythmia. In collaboration with the Department of Biomedical Engineering in the Case Western Reserve University School of Engineering, faculty members are investigating methods to optimally treat atrial fibrillation.

Environmental Factors in Disease
A large program in environmental exposures allows investigation of fundamental mechanisms by which diverse environmental factors in the physical and social environment may results in propensity for cardiometabolic disease. Air pollution exposures through real world exposures in Cleveland using a versatile aerosol concentration enrichment system (VACES).


